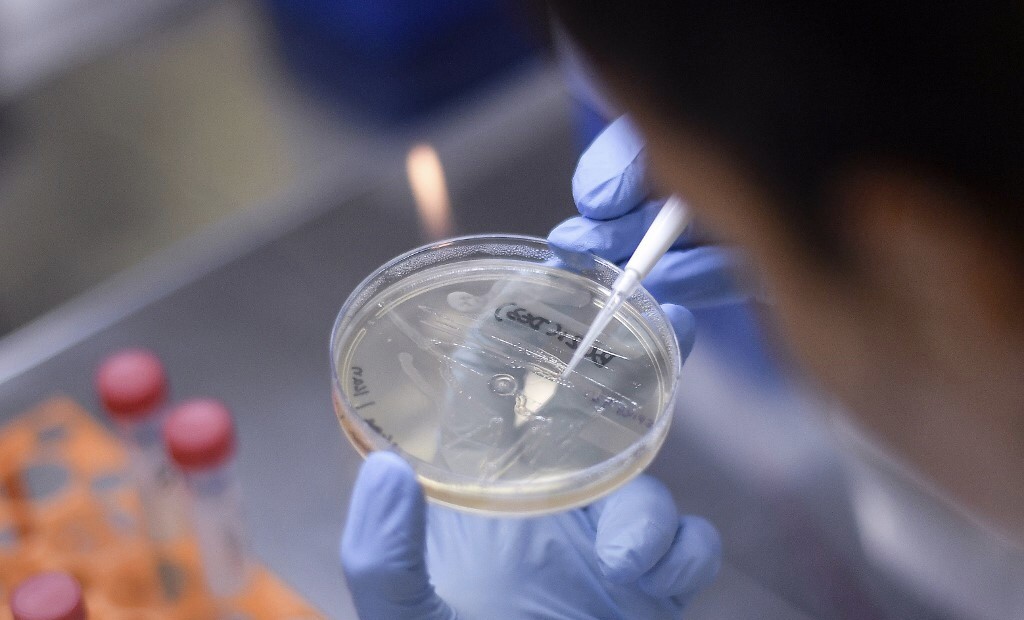
Vaksin Virus Corona Bisa Tersedia September 2020, Hasil Kerja Keras Universitas Oxford

Vaksin Virus Corona Bisa Tersedia September 2020, Hasil Kerja Keras Universitas Oxford

LONDON, iNews.id - Ilmuwan Inggris bekerja keras membuat vaksin virus corona. Paling cepat, vaksin Covid-19 tersedia pada September 2020.
Ahli vaksinologi Universitas Oxford Sarah Gilbert, kepada surat kabar The Times, yakin vaksin 80 persen bekerja dengan baik dan siap digunakan pada September.

Pencapaian yang dilakukan para ahli dari Inggris ini cukup mengejutkan, pasalnya para pakar lain memperkirakan vaksin akan tersedia dalam 12 sampai 18 bulan. Butuh waktu lama untuk mengembangkan vaksin karena tergolong baru. Waktu 12 sampai 18 bulan merupakan patokan dalam penemuan vaksin wabah sebelumnya, termasuk Ebola.
Meski demikian Gilbert meyakinkan bahwa prediksi waktu September bukan dugaan semata.
Studi: Orang Meninggal akibat Corona di Inggris Bisa Capai 60.000 Jiwa Bulan Ini
"Ini bukan sekadar dugaan Setiap pekan berlalu, kami punya lebih banyak data untuk dilihat," kata Gilbert, seperti dilaporkan kembali Bloomberg.